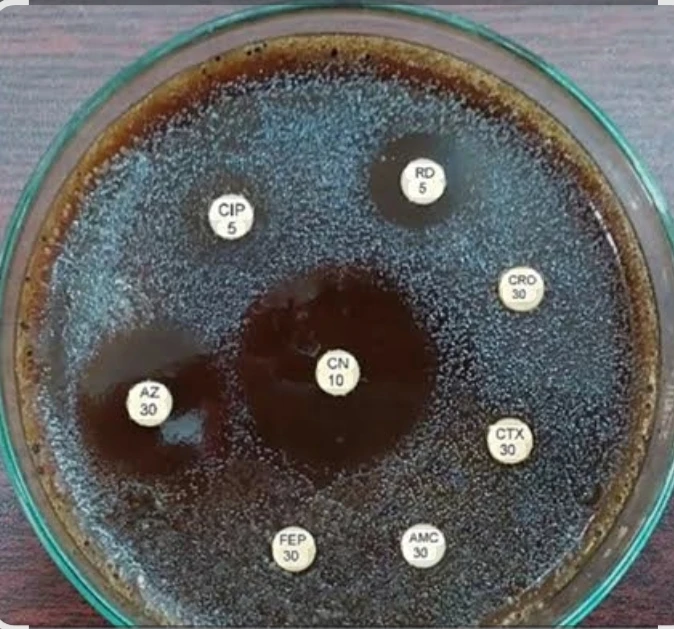
Culture & Sensitivity - Urethral Discharge

تفاصيل التحليل
الثقافة والحساسية - إفرازات مجرى البول
تشخيص دقيق للإفرازات والألم البولي! تساعد هذه الباقة في تحديد البكتيريا أو الميكروبات المسببة لالتهاب الإحليل (مثل السيلان، الكلاميديا)، ومعرفة المضاد الحيوي الأنسب للعلاج. خطوة ضرورية للعلاج الفعال ومنع المضاعفات.
الصورة التوضيحية المرتبطة بهذا التحليل